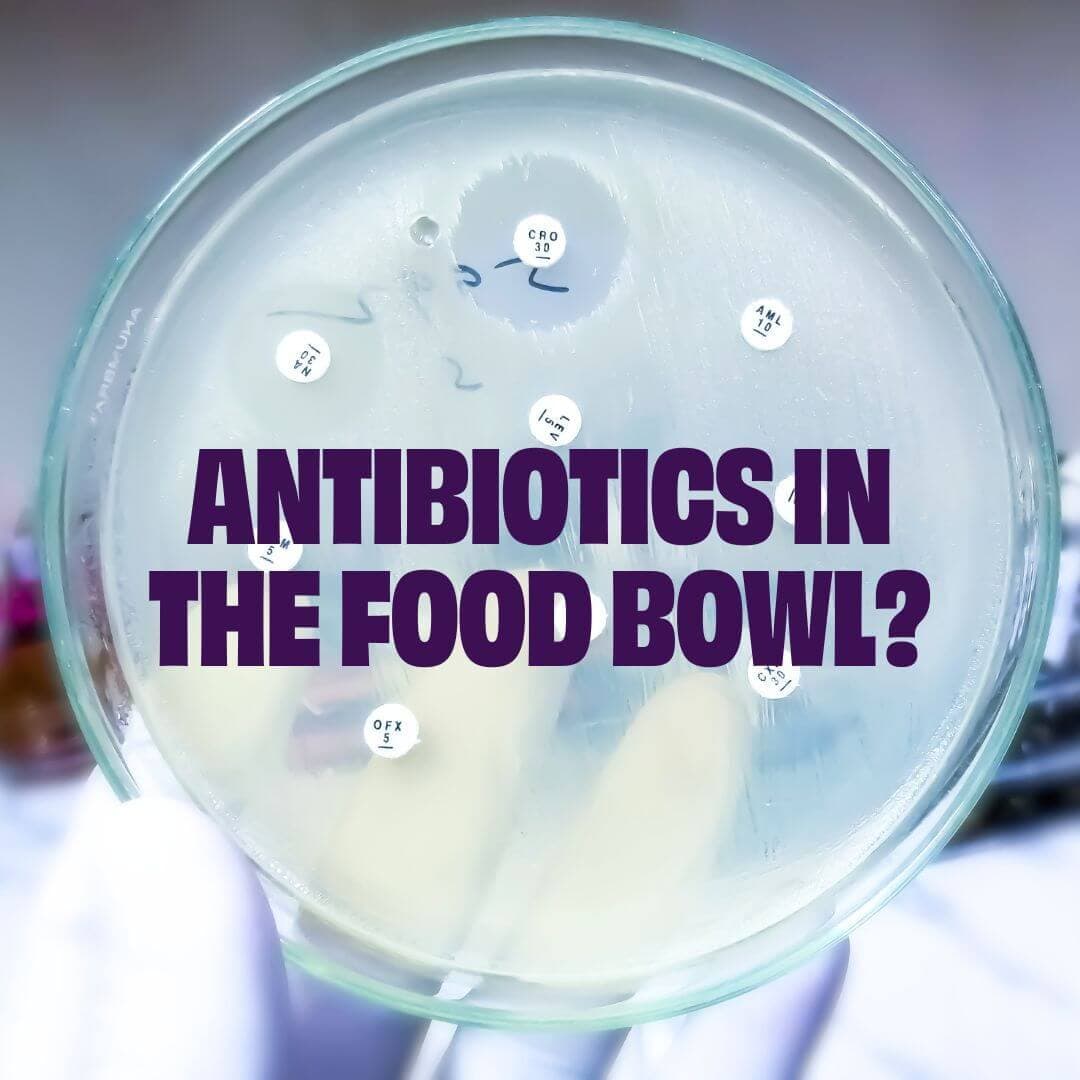
https://a.storyblok.com/f/236174/1080x1080/c63a1190b4/antibiotics-problem-eng.jpg

Active location:
Select your country:

Insekten = Keine Antibiotika

Problem: 70% aller Antibiotika werden in der Tierindustrie eingesetzt.
Die Entdeckung von Antibiotika hat die Gesundheitsversorgung revolutioniert. Allerdings führte ihr weit verbreiteter Einsatz zu Resistenzen. Dieses wachsende Problem der Antibiotikaresistenz wird von der WHO als eine der größten globalen Gesundheitsbedrohungen eingestuft.
Antibiotikaresistenz (AMR) ist eine wachsende globale Bedrohung, bei der Bakterien und andere Krankheitserreger Resistenzen entwickeln und nicht mehr auf Antibiotika ansprechen. Laut der WHO ist AMR eine der größten Bedrohungen für die globale Gesundheit, mit einer geschätzten 4,95 Millionen Todesfälle im Zusammenhang mit AMR jedes Jahr.
Das Problem der Antibiotikaresistenz wurde durch den übermäßigen Einsatz und Missbrauch von Antibiotika beschleunigt, insbesondere in der Lebensmittelproduktion, wo ein klarer Zusammenhang zwischen schlechtem Tierschutz und dem umfangreichen Einsatz von Antibiotika besteht.
Ungefähr 73% aller Antibiotika Weltweit verkaufte Antibiotika werden in der Tierproduktion eingesetzt, einschließlich bei Fleisch produzierenden Tieren. Mit anderen Worten, Mehr Antibiotika werden für gesunde Tiere verwendet als für kranke Menschen!
Die globale Fleischindustrie, in der unnötigerweise Antibiotika eingesetzt werden, trägt maßgeblich zur Verbreitung von Antibiotikaresistenzen bei. Haustiere, die 25% des weltweiten FleischkonsumsDaher werden sie Teil des Problems. Die Nachfrage nach Fleisch in Tiernahrung treibt indirekt den übermäßigen Einsatz von Antibiotika in der Tierproduktion an und trägt zur globalen AMR-Krise bei.

Risiken: Wie wirkt sich meine Wahl des Tierfutters darauf aus?
Das Füttern von Hunden und Katzen mit Fleisch unbekannter Herkunft kann das Risiko erhöhen, zur Verbreitung von Antibiotikaresistenzen beizutragen. Wenn die Quelle des Fleisches in Hunde- oder Katzenfutter unbekannt ist, ist es auch schwierig, Transparenz darüber zu haben, wie Antibiotika eingesetzt wurden. Bestimmte Arten von Hunde- und Katzenfutter wurden auch als besonderes Risiko für die Verbreitung von antibiotikaresistenten Bakterien auf das Haustier oder Familienmitglieder identifiziert.
Die Transparenz bezüglich der Herkunft von Fleisch in Hunde- oder Katzenfutter und wie Antibiotika auf diesem bestimmten Bauernhof gehandhabt wurden, ist oft äußerst begrenzt. Hunde und Katzen mit Fleisch unbekannter Herkunft zu füttern, kann daher das Risiko erhöhen, zur Verbreitung von Antibiotikaresistenzen beizutragen.
Wenn Sie Ihrem Hund oder Ihrer Katze rohes Futter geben, sind Sie und Ihr Haustier einem größeren Risiko direkter Exposition ausgesetzt. antibiotikaresistente BakterienStudien haben gezeigt, dass rohe Lebensmittel mit rohem Fleisch eine potenzielle Quelle für antibiotikaresistente Krankheitserreger sein können, die sich auch verbreiten können. durch den Kot des HundesDas bedeutet, dass Haustiere, die mit solchem Futter gefüttert werden, diese Bakterien tragen können. Dies erhöht nicht nur das Risiko von schwer zu behandelnden Infektionen beim Hund oder der Katze, sondern kann auch zur Verbreitung von Bakterien in der häuslichen Umgebung und auf Menschen führen.
Für Familien birgt das Leben mit einem Haustier, das resistente Bakterien trägt, ein Risiko. Die Bakterien können sich durch direkten Kontakt mit dem Hund oder der Katze, durch Speichel oder Kot oder über Oberflächen, die das Haustier berührt, verbreiten. Das bedeutet, dass Familienmitglieder - insbesondere kleine Kinder, ältere Menschen oder Personen mit geschwächtem Immunsystem - resistente Bakterien ausgesetzt sein können, die schwer zu behandeln sind. Forschungen zeigen, dass das Risiko der Übertragung dieser Bakterien von Tieren auf Menschen in Haushalten besonders hoch sein kann. wo rohes Essen verwendet wirdDaher ist es wichtig, Lebensmitteloptionen in Betracht zu ziehen, die nicht nur für das Haustier, sondern auch für die gesamte Familie sicher sind.

Lösung: Petgood ist zu 100% frei von Antibiotika.
Um die Ausbreitung von Antibiotikaresistenzen zu reduzieren und gleichzeitig sowohl Ihr Haustier als auch Ihre Familie zu schützen, ist es entscheidend, Lebensmittel zu wählen, die ohne Antibiotika hergestellt werden und eine vollständige Rückverfolgbarkeit bieten.
Sie erreichen dies mit dem insektenbasierten Futter von Petgood - durch die Verwendung von Protein aus den Larven der Schwarzen Soldatenfliege, die während der Zucht niemals Antibiotika benötigen, wird das Risiko der Förderung von Antibiotikaresistenzen vollständig eliminiert.
Indem Sie Petgood wählen, können Sie sicher sein, dass Ihr Hund oder Ihre Katze ein ernährungstechnisch fantastisches Futter erhält, und Sie leisten auch einen aktiven Beitrag zum Schutz sowohl Ihres Haustiers, Ihrer Familie als auch unseres Planeten vor Antibiotikaresistenzen.
Die Larven werden in einer sauberen und natürlichen Umgebung aufgezogen, um die Verbreitung von Krankheiten zu minimieren. Sie haben auch ein ausgezeichnetes Immunsystem und sind von Natur aus widerstandsfähig gegen Krankheiten, wachsen schnell von selbst, ohne dass Wachstumsförderer benötigt werden - fantastische Eigenschaften, die sie von anderen Tieren unterscheiden.

Petgood erfüllt die Antibiotika-Kriterien der Axfoundation.
Wir sind stolz darauf, dass alle unsere insektenbasierten Tiernahrungsmittelprodukte den strengen Anforderungen der Axfoundation entsprechen. Antibiotika-KriterienPlease provide the text that you would like me to translate into German. im Anschluss an eine Selbstbewertung anhand dieser Standards.
Die Kriterien dienen als Leitfaden für den verantwortungsbewussten Einsatz von Antibiotika und den Tierschutz in der Lebensmittelproduktion. Das Ziel ist es, den Antibiotikaeinsatz zu reduzieren und der globalen Ausbreitung von Antibiotikaresistenzen entgegenzuwirken.
Petgoods Leistung im Treffen diese Kriterien Dies markiert einen bedeutenden Schritt nach vorne im Beitrag der Tiernahrungsindustrie zur Bekämpfung der antimikrobiellen Resistenz. Durch die Verwendung von innovativem, antibiotikafreiem Insektenprotein stellt Petgood nicht nur die Gesundheit und das Wohlergehen von Haustieren sicher, sondern adressiert auch eine kritische globale Herausforderung.
Die Tatsache, dass die Produktion von Insektenprotein nicht auf unerwünschten Zusätzen wie Antibiotika beruht, zeigt deutlich die sehr hohe Qualität dieses nahrhaften Futtermittelinhalts. Die Reduzierung unserer Abhängigkeit von Antimikrobiellen ist entscheidend, um die globale Gesundheitskrise der AMR zu bekämpfen; und die Produktion von Insektenprotein ist ein Vorreiter auf diesem Gebiet.
- Dr. Nicky Sluczanowski, Leitende Tierärztin, Petgood